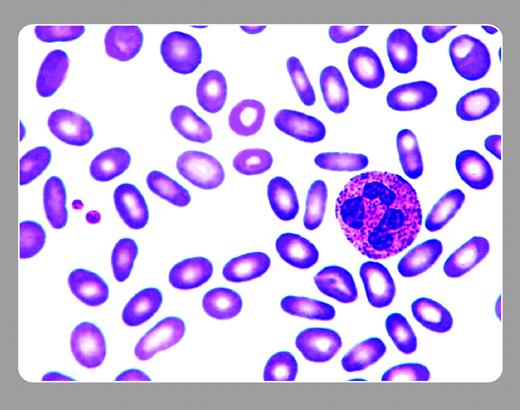

A 29-year-old white male who visits the emergency room after an auto injury is noted to have mild anemia (hemoglobin level 111 g/L) and a palpable spleen tip. He has a number of laboratory tests drawn, including those for HIV, EB, CMV, and hepatitis. A hematology consultant sees him and asks, “Anyone in your family with anemia or an enlarged spleen?” He answers affirmatively.
The peripheral smear shows a prominence of uniformly elliptical cells. Given the positive family history, the smear is indicative of hereditary elliptocytosis (HE). This relatively common hereditary hemolytic anemia is autosomal dominant in transmission. Most patients are not anemic because of a compensated hemolytic anemia. But approximately 10% have a mild degree of anemia and splenomegaly. The history and a review of the peripheral smear usually make the diagnosis.
Neil Abramson, Baptist Cancer Institute
A 29-year-old white male who visits the emergency room after an auto injury is noted to have mild anemia (hemoglobin level 111 g/L) and a palpable spleen tip. He has a number of laboratory tests drawn, including those for HIV, EB, CMV, and hepatitis. A hematology consultant sees him and asks, “Anyone in your family with anemia or an enlarged spleen?” He answers affirmatively.
The peripheral smear shows a prominence of uniformly elliptical cells. Given the positive family history, the smear is indicative of hereditary elliptocytosis (HE). This relatively common hereditary hemolytic anemia is autosomal dominant in transmission. Most patients are not anemic because of a compensated hemolytic anemia. But approximately 10% have a mild degree of anemia and splenomegaly. The history and a review of the peripheral smear usually make the diagnosis.
Neil Abramson, Baptist Cancer Institute
Many Blood Work images are provided by the ASH IMAGE BANK, a reference and teaching tool that is continually updated with new atlas images and images of case studies. For more information or to contribute to the Image Bank, visit www.ashimagebank.org.
This feature is available to Subscribers Only
Sign In or Create an Account Close Modal